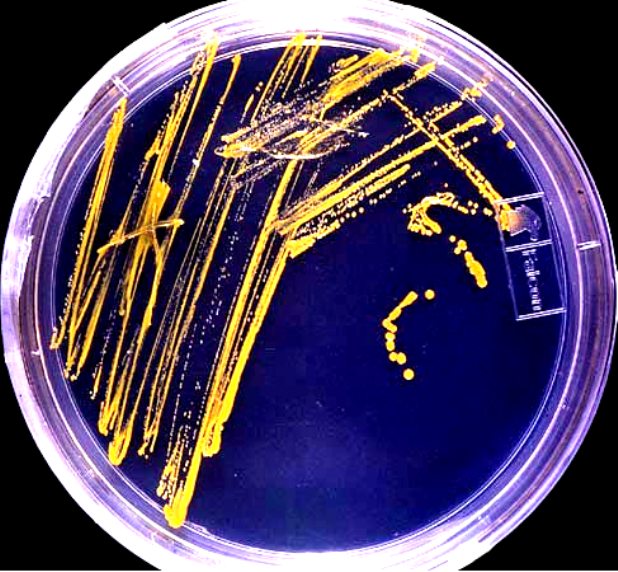
O bakteriach w Śląskiej Kawiarni Naukowej

Spotkanie tym razem będzie poświęcone bakteriom. Dr Tomasz Rożek, szef Śląskiej Kawiarni Naukowej, będzie rozmawiał z dr. Sławomirem Sułowiczem, mikrobiologiem środowiskowym, pracownikiem Katedry Mikrobiologii Uniwersytetu Śląskiego w Katowicach.
Czasami przyjaźń pomiędzy ludźmi i bakteriami bywa toksyczna, ale nie ma wątpliwości, że bez nich nie byłoby nas. W ludzkim ciele jest więcej komórek bakteryjnych niż komórek ludzkich. Pomagają nam trawić, uodparniają i chronią np. przed grzybami. Ale nie powinniśmy dać się zwieść. Nie brakuje w naszym otoczeniu takich szczepów, które są dla nas śmiertelnie niebezpieczne. Gość Śląskiej Kawiarni Naukowej spróbuje odpowiedzieć m.in. na takie pytania, jak:
- jak długo trzeba myć dłonie, żeby pozbyć się bakterii?
- czy bakterie mogą kiedyś zawładnąć Ziemią?
- ile prawdy jest w stwierdzeniu "częste mycie skraca życie"?
- skąd bakterie wzięły się na mnie i we mnie?